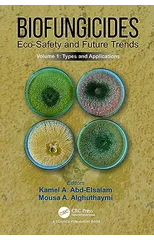
Biofungicides

Books by Kamel A. Abd-Elsalam
Kamel A. Abd-Elsalam
Filter
Biofungicides
Eco-Safety and Future Trends : Types and Applications, Volume 1
Kamel A. Abd-Elsalam
Paperback
Published:
2025